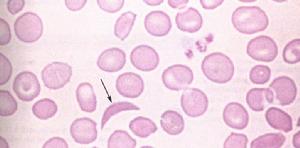
鐮狀細胞性貧血

簡介
 鐮狀細胞性貧血
鐮狀細胞性貧血症狀
此病的症狀包括:精神不振和呼吸急促、出現黃疸症狀、骨骼及胸部或腹部出現劇烈疼痛,這是因為狹窄的血管阻塞所致。脫水、感冒或嚴重的感染更容易引發前述症狀。
併發症
鐮狀細胞性貧血的患兒較容易患有雙球菌肺炎。有時也會出現腎臟、脾臟或腦部供血不足的情況,從而造成這些器官受損。
 |  |
| 鐮狀細胞性貧血肘關節改變1 | 鐮狀細胞性貧血肘關節改變2 |
 |  |
| 鐮狀細胞性貧血導致顱骨改變 | 鐮狀細胞性貧血導致腦改變 |
發病機制
 鐮狀細胞性貧血
鐮狀細胞性貧血鐮狀細胞貧血由β鏈基因點突變引起,珠蛋白的β基因發生單一鹼基突變。正常β基因的第6位密碼子為GAG,編碼谷氨酸,突變後為GTG,編碼纈氨酸,使成為HbS.在純合子狀態,當形成HbS後,HbS在脫氧狀態下聚集成多聚體,因形成的多聚體排列方向與膜平行,與細胞膜的接觸又非常緊密,所以當多聚體達到一定量時,細胞膜便由正常的雙凹形盤狀變成鐮刀形.該細胞僵硬,變形性差,易破而溶血,造成血管阻塞,組織缺氧,損傷,壞死。
若孩子從父母雙方各遺傳得到一個異常基因,那么他就會發生鐮狀細胞性貧血。但如果孩子只從雙親的一方遺傳到一個異常基因,則他會帶有鐮狀細胞性貧血的特質,即雖不會出現症狀,但會把異常基因遺傳給下代。
應對措施
鐮狀細胞性貧血
鐮狀細胞性貧血如果孩子出現任何一種上述症狀,就應該帶孩子去醫院檢查,血液檢驗可以確認診斷(許多患兒都是在出生驗血時檢測出來的)。治療方式包括補允葉酸以減輕貧血的嚴重性,服用青黴素以防止感染,進行免疫接種以防止肺炎感染,而且有必要的話,也可以服用止痛劑。為了防止疼痛發作,你應該確保孩子飲用大量的水,並且避免孩十受寒。
 鐮狀細胞性貧血
鐮狀細胞性貧血如果孩子出現疼痛發作,並且並發以下的症狀,如發燒、膚色突然變白、反覆嘔吐或嚴重腹瀉、呼吸困難或呼吸急促、異常睏倦或精神不振等,這時就應該立即帶孩子去醫院就診。
疾病診斷
 鐮狀細胞性貧血基因診斷
鐮狀細胞性貧血基因診斷鐮狀紅細胞貧血症的基因診斷可採用PCR-限制性內切酶譜分析法,先用PCR從患者基因組DNA擴增含突變位點的珠蛋白基因片段,再選擇適當的限制性內切酶水解PCR產物,根據酶切產物在電泳圖譜上的片段數量和大小做出判斷.也可與特意的寡核苷酸探針進行Southern印記雜交分析,根據雜交圖譜做出判斷.
疾病治療
在良好的醫療照料下,大多數的鐮狀細胞性貧血患兒都可以長大成人。假如孩子的病情非常嚴重,而且又能找到合適的骨髓捐贈人,那么可以考慮實施骨髓移植。一旦骨髓移植成功,此病就可完全痊癒。
疾病預防
 血液檢查
血液檢查屬於此高危險群的人們最好接受血液檢驗,以便查出他們是否具有異常的基因。假如胎兒有鐮狀細胞性貧血,應該考慮終止妊娠。
研究進展
 全球研究進展
全球研究進展各國政府已加大投入,加強相關知識的宣傳力度,重視治療和關懷,尤其是推廣良好的孕婦產前篩查和診斷,避免鐮狀細胞性貧血嬰兒的降生。國際鐮狀細胞性貧血大會討論防治鐮狀細胞性貧血的措施,來自五大洲的有關研究人員、專家研究如何提高人們對預防這種常見遺傳性貧血病的認識。

